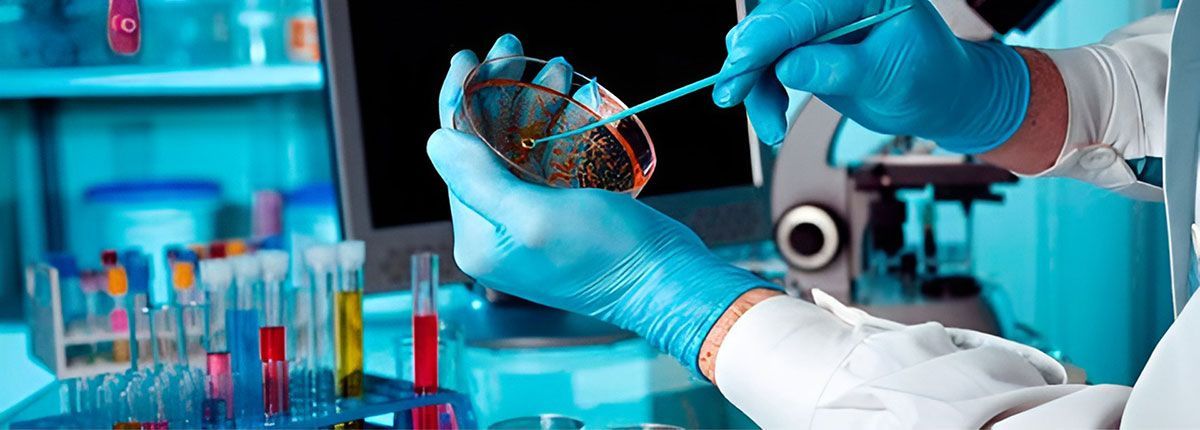
LABORATORIO DE ANÁLISIS CLÍNICOS ÁNGELES

Laboratorio de análisis clínicos
Se encuentra en Los Mochis para ofrecerte estudios médicos, ¡llámanos!

Acerca de LABORATORIO DE ANÁLISIS CLÍNICOS ÁNGELES
Resultados confiables
Si necesitas estudios médicos de glucosa, química sanguínea o una prueba de embarazo, te esperamos en LABORATORIO DE ANÁLISIS CLÍNICOS ÁNGELES en Los Mochis, Sinaloa.
Proporcionamos atención rápida, personalizada, amable y efectiva para que tengas estudios médicos confiables con absoluta calidad.
Somos un laboratorio de análisis clínicos con más de 36 años experiencia atendiendo en nuestras instalaciones o incluso a domicilio, para que tengas los exámenes más precisos.
Contamos con un equipo de trabajo y colaborador, comprometido con proporcionarte tus estudios médicos con equipos que tienen tecnología de vanguardia.
Nuestro laboratorio clínico tiene la mejor infraestructura, con instalaciones diseñadas para tu comodidad y tranquilidad en el momento cuando se realicen tus estudios.
Somos un laboratorio certificado por la Federación Nacional de Químicos Clínicos (Conaquic).
¡Te esperamos!
Te proporcionamos resultados 100 % garantizados y confiables
En LABORATORIO DE ANÁLISIS CLÍNICOS ÁNGELES te brindamos seguridad, confianza y calidad en cada uno de los estudios médicos que realizamos a nuestros pacientes.
Ofrecemos resultados confidenciales, 100 % confiables y garantizados.
Llámanos y con gusto te brindaremos la atención requerida.

Estudios de rutina

- Ácido úrico
- Colesterol
- Triglicéridos

- Glucosa
- Urea y creatinina
- Perfil hepático

- Pruebas de funcionamiento hepático
- Perfil de lípidos
- Perfil reumatoide
Análisis clínicos

- Prueba de embarazo
- Beta hormona gonadotropina
- Antidoping
- Enfermedades de transmisión sexual

- Grupo sanguíneo y RH
- Papanicolaou
- Virus del Papiloma Humano (VPH)
- Tipificación (PCR)

- Pruebas de paternidad - ADN
- Biología molecular
- Química sanguínea
- Inmunología
En Laboratorio de Análisis Clínicos Ángeles realizamos pruebas de ADN confiables y seguras, con resultados totalmente confidenciales.
Ya sea para confirmar
paternidad, maternidad o parentesco, contamos con la tecnología adecuada y personal altamente capacitado para brindarte la certeza que necesitas.
Resultados precisos y confidenciales
Muestras rápidas, indoloras y seguras
Asesoría personalizada en cada paso
Laboratorio certificado y de confianza en Los Mochis
Toma decisiones con seguridad y respaldo científico.
En Ángeles, tu tranquilidad y la de tu familia son nuestra prioridad.



¡Contacta a Laboratorio de Análisis Clínicos Ángeles y solicita estudios médicos!
Contact Us
Gracias por contactarnos.
Nos pondremos en contacto con usted tan pronto como sea posible
Ups, hubo un error al enviar tu mensaje.
Por favor, inténtelo de nuevo más tarde

